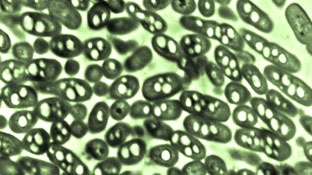
Tạo ra xăng từ vi khuẩn

Trong số các thương hiệu đang có mặt trên thị trường, Haruco nổi bật với các dòng đai lưng được thiết kế chuyên biệt cho nhiều đối tượng sử dụng khác nhau.
-
Dầu dừa giúp chống sâu răng

-
Lợi ích sức khỏe của hạt bí

-
Tranh cãi xung quanh việc sử dụng hình ảnh MRI trong xử án

Gary Smith nói rằng anh không sát hại người bạn cùng phòng nhưng các công tố viên ở Hạt Montgomery thì cho rằng chính anh là thủ phạm. Liệu công nghệ quét não có thể chứng minh người này đang nói thật hay nói dối hay không? Câu hỏi này đang gây ra cuộc tranh luận sôi nổi giữa các nhà khoa học và giới tư pháp Mỹ.
-
Thiền xua tan cảm giác cô đơn và bệnh tật ở người lớn tuổi

-
Món ăn ngon cũng có tác dụng như thuốc trị trầm cảm

-
Sô-cô-la giảm nguy cơ đột quị ở nam giới

-
Khi nào chúng ta mới thực sự cần phải xét nghiệm?

Ngày nay, mỗi khi đi khám bệnh, bệnh nhân thường được bác sĩ yêu cầu thực hiện hàng loạt cuộc kiểm tra, như xét nghiệm máu, đo điện tâm đồ, siêu âm Một số xét nghiệm có thể xem là hữu ích, số khác chỉ khiến bệnh nhân lãng phí thời gian và tiền bạc, thậm chí rất hại cho sức khỏe. Chính vì vậy, các chuyên gia y tế Mỹ kêu gọi các bác sĩ và bệnh nhân nên suy nghĩ 2 lần trước khi quyết định làm các xét nghiệm không cần thiết.
-
Bếp nấu kiêm máy phát điện Score-Stove

-
Tạo ra xăng từ vi khuẩn
-
Tua-bin “thần kỳ” tạo ra nước sạch từ không khí

-
Năm 2050, con người có thể phải ăn chay để bảo vệ tài nguyên

-
"Cơ sở hạ tầng xanh" - giải pháp hạn chế ô nhiễm nguồn nước

-
Review đai lưng bảo vệ cột sống của thương hiệu Haruco

- Điểm sáng ứng dụng công nghệ hiện đại trong chẩn đoán hình ảnh và xét nghiệm của y tế Cần Thơ
- Tất cả các cơ sở y tế đều tư vấn, xét nghiệm HIV, viêm gan B và giang mai cho phụ nữ mang thai
- Sở Y tế TP Cần Thơ thẩm định cấp phép hoạt động cho Phòng khám Đa khoa Hòa Hảo - Long Mỹ
- Buồng trứng đa nang có tự khỏi được không? Hiểu đúng sẽ giúp bạn vượt qua hội chứng này
- Chia sẻ kinh nghiệm dự phòng lây truyền HIV, giang mai và viêm gan B từ mẹ sang con
- Mổ 2 giai đoạn điều trị bệnh rò đại tràng sigma - bàng quang phức tạp
- Đẩy mạnh dự phòng HIV, giang mai và viêm gan B ở trạm y tế
- Cảnh báo về loại ma túy cực độc fentanyl, độc tính cao gấp 50 lần so với heroine
- Bệnh răng miệng có thể làm tăng nguy cơ đột quỵ
-
Quy định mới của Bộ Y tế về khám sức khỏe trước khi kết hôn

- Các bệnh viện ở Cần Thơ diễn tập báo động đỏ ngoại viện
- Báo động xu hướng gia tăng ca bệnh sốt xuất huyết nặng tại ĐBSCL
- Tiếp nối hành trình trong chuỗi Chăm sóc sức khỏe cộng đồng của Bệnh viện Quốc tế Phương Châu Sóc Trăng
- Cập nhật những tiến bộ mới trong phẫu thuật và can thiệp cấp cứu bệnh lý động mạch chủ
- Cảnh báo về loại ma túy cực độc fentanyl, độc tính cao gấp 50 lần so với heroine
- 6 nhiệm vụ trọng tâm nâng cao chất lượng chăm sóc sức khỏe nhân dân Cần Thơ theo Nghị quyết 72/NQ-TW
- Mổ 2 giai đoạn điều trị bệnh rò đại tràng sigma - bàng quang phức tạp
- Tác hại của ăn một mình đối với người cao tuổi
- Những nghiên cứu giúp giảm gánh nặng do bệnh tim mạch
-

Vinmec Cần Thơ chính thức áp dụng khám chữa bệnh Bảo hiểm Y tế
-

Ăn trái cây giàu vitamin C trực tiếp sinh collagen và tái tạo da
-

Kỹ thuật đặc biệt giúp người đàn ông tìm lại nụ cười sau hơn một năm bị co giật nửa mặt
-

Người đi tìm những “mảnh ghép” còn thiếu trong hành trình giải mã bệnh hiếm
-

Phẫu thuật nội soi cứu sống cụ bà 80 tuổi mắc ung thư dạ dày ở vùng “tử huyệt”








































